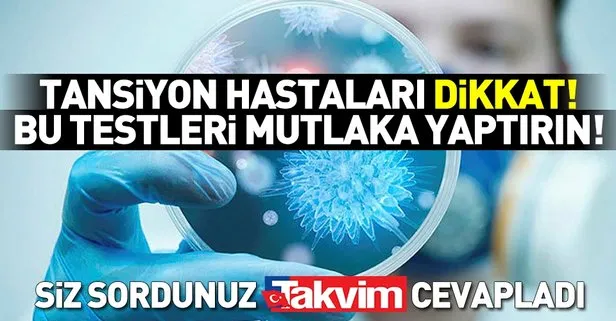

Tansiyon Hastalýðýna Hangi Doktor Bakar

Yuksek Tansiyon Icin Hangi Bolume Doktora Gidilir Saglik Son Dakika Haberler

Tansiyona Hangi Bolum Bakar Modanium

Tansiyon Icin Hangi Bolume Gidilir Yuksek Tansiyon Ve Dusuk Tansiyon Icin Hangi Doktordan Randevu Alinmalidir Saglik Haberleri

Tansiyon Icin Hangi Bolumden Randevu Alinir Yuksek Tansiyon Icin Hangi Doktora Gitmeli

Yuksek Tansiyona Hangi Bolum Bakar Modanium

Tansiyon Icin Hangi Doktora Gidilir

Hangi Hastaliklara Hangi Bolum Bakar Son Dakika Haberler

Yuksek Tansiyon Icin Hangi Bolume Doktora Gidilir Saglik Son Dakika Haberler

Odem Icin Hangi Bolume Doktora Gidilir Saglik Son Dakika Haberler

Yuksek Tansiyon Icin Hangi Bolume Doktora Gidilir Saglik Son Dakika Haberler

Tansiyon Yuksekligi Dusuklugu Icin Hangi Bolume Poliklinige Gitmek Gerekir Saglik Haberleri

Hangi Hastaliklar Icin Hangi Doktora Gitmek Gerekir Ozel Optimed Hastanesi

Yuksek Tansiyon Hipertansiyon Tedavisi Ameliyat Com

Mide Agrisi Icin Hangi Doktora Bolume Gidilir Mide Agrisina Hangi Doktor Bakar Nereden Ve Hangi Bolumden Randevu Alinir Son Dakika Haberler

Hangi Doktora Gidilir Hangi Doktor Bakar Hangi Bolume Gidilir

Yuksek Tansiyon Icin Hangi Bolume Doktora Gidilir Start Magazine

Hangi Bolume Hangi Doktor Bakar

Hangi Hastaliga Hangi Bolum Hangi Doktor Bakar

Hangi Hastaliga Hangi Doktor Bakar Hangi Bolum Icin Hangi Doktordan Randevu Alinir Fotograf 21

Tansiyon Icin Hangi Bolumden Randevu Alinir

Ense Agrisina Hangi Bolum Doktor Bakar Saglik Son Dakika Haberler

Kalp Yetmezligi Icin Hangi Bolume Doktora Gidilir Saglik Son Dakika Haberler

Kardiyoloji Nedir Neye Bakar Kalp Damar Cerrahisi Bolumu Doktoru Kardiyolog Hangi Hastaliklara Bakiyor Saglik Haberleri

Seker Hastaligina Hangi Bolum Bakar Dora Hospital Hastanesi

Tansiyon Sorunu Olup Olmadigini Ogrenmek Icin Hangi Hekime Gidilmeli

Dahiliye Nedir Dahiliye Hangi Hastaliklara Bakar Uzmani Ve Doktoru Neye Bakar Saglik Haberleri

Dahiliye Hangi Hastaliklara Bakar Dahiliye Neye Bakar Dahiliye Nelere Bakar

Hangi Hastalik Icin Hangi Doktora Gidilmeli Interaktif Adam

Dahiliye Nedir Dahiliye Ne Demek Dahiliye Doktoru Neye Ve Hangi Hastaliklara Bakar Saglik Haberleri

Bas Agrisi Icin Hangi Bolume Gidilir Hangi Bolume Hangi Doktor Bakiyor Takvim

Uroloji Nedir Neye Bakar Uroloji Bevliye Bolumu Doktoru Urolog Hangi Hastaliklara Bakiyor Saglik Haberleri

Yuksek Tansiyon Icin Hangi Bolume Doktora Gidilir Saglik Son Dakika Haberler

Mide Muayenesi Icin Hangi Bolume Gidilir

Boyun Agrisi Icin Hangi Bolume Gidilir Boyunda Olan Agri Icin Hangi Doktordan Randevu Alinmalidir Saglik Haberleri

Tansiyon Sorunu Olup Olmadigini Ogrenmek Icin Hangi Hekime Gidilmeli

Romatoloji Nedir Romatoloji Hangi Hastaliklara Bakar Uzmani Ve Doktoru Neye Bakar Saglik Haberleri

Hastanede Hangi Hastaliga Hangi Bolum Bakar Haberler

Uyku Apnesi Icin Hangi Doktora Gidilir Uyku Apnesine Hangi Bolum Bakar Saglik Haberleri

Uroloji Nedir Hangi Hastaliklara Bakar Saglik Haberleri

Hangi Hastaliga Hangi Doktor Bakar Hangi Bolum Icin Hangi Doktordan Randevu Alinir Fotograf 21

Endokrinoloji Nedir Endokrinoloji Hangi Hastaliklara Bakar Uzmani Ve Doktoru Neye Bakar Saglik Haberleri

Hangi Hastaliga Hangi Doktor Bakar Hangi Bolum Icin Hangi Doktordan Randevu Alinir Fotograf 21

Bas Agrisi Icin Hangi Bolume Ve Doktora Gidilir Bas Agrisina Bakan Poliklinikten Nasil Randevu Alinir

Tansiyon Icin Hangi Doktora Gidilir Hangi Bolum Bakar

Hangi Hastaliga Hangi Brans Bakar

Nefroloji Nedir Hangi Hastaliklara Bakar Saglik Son Dakika Haberler

Ayak Sismesi Neden Olur Ne Iyi Gelir Ayak Sisligi Icin Hangi Doktora Gidilir

Boyun Agrisi Icin Hangi Doktora Gidilir
Tansiyon Hastalari Dikkat Bu Testleri Mutlaka Yaptirin Takvim

Regl Agrisi Icin Hangi Bolume Doktora Gidilir Saglik Son Dakika Haberler

Yuksek Tansiyon Hastaligi Hangi Belirtileri Verir Youtube

Idrar Kacirma Icin Hangi Bolume Doktora Gidilir Saglik Son Dakika Haberler

Hangi Hastaliga Hangi Doktor Bakar Hangi Bolum Icin Hangi Doktordan Randevu Alinir Fotograf 21

Gogus Hastaliklari Nedir Neye Bakar Gogus Hastaliklari Bolumu Doktoru Hangi Hastaliklara Bakiyor Saglik Haberleri

Tansiyon Icin Hangi Bolumden Randevu Alinir Yuksek Tansiyon Icin Hangi Doktora Gitmeli

Tansiyon Icin Hangi Bolumden Randevu Alinir Yuksek Tansiyon Icin Hangi Doktora Gitmeli

Beyin Ve Sinir Cerrahisi Norosirurji Nedir Hangi Hastaliklara Bakar Saglik Son Dakika Haberler

Tansiyon Sorunu Olup Olmadigini Ogrenmek Icin Hangi Hekime Gidilmeli

Endokrinoloji Nedir Hangi Hastaliklara Bakar Saglik Son Dakika Haberler

Hangi Hastaliga Hangi Bolum Doktor Bakiyor Hangi Hastalik Icin Hangi Doktordan Hangi Bolumden Randevu Alinir

Yuksek Tansiyon Icin Hangi Bolume Doktora Gidilir

Hangi Hastaliga Hangi Doktor Bakar Hangi Bolum Icin Hangi Doktordan Randevu Alinir Fotograf 21

Hangi Hastaliga Hangi Bolum Bakar Poliklinik

Gogus Agrisi Icin Hangi Bolum Doktora Gidilir Gogus Agrisina Hangi Doktor Bakar Son Dakika Haberler

Tansiyon Icin Hangi Bolumden Randevu Alinir Yuksek Tansiyon Icin Hangi Doktora Gitmeli

Bas Agrisi Icin Hangi Bolume Doktora Gidilir Saglik Son Dakika Haberler

Tansiyon Icin Hangi Bolumden Randevu Alinir Yuksek Tansiyon Icin Hangi Doktora Gitmeli

Tansiyon Sorunu Olup Olmadigini Ogrenmek Icin Hangi Hekime Gidilmeli

Hangi Hastaliga Hangi Bolumden Randevu Alinir

Tansiyon Icin Hangi Bolumden Randevu Alinir

Hangi Hastaliga Hangi Doktor Bakar Hangi Bolum Icin Hangi Doktordan Randevu Alinir Fotograf 21

Hangi Hastaliga Hangi Brans Bakar

Tansiyon Sorunu Olup Olmadigini Ogrenmek Icin Hangi Hekime Gidilmeli

Nefroloji Nedir Hangi Hastaliga Bakar Son Dakika Haberler

Dahiliye Nedir Hangi Hastaliklara Bakar Tam Liste Saglik Haberleri

Idrar Kacirma Problemi Icin Hangi Doktora Gidilir

Tansiyon Holteri Nedir Tansiyon Holteri Nasil Takilir Prof Dr Ilke Sipahi Kardiyoloji Uz Youtube

Kardiyoloji Nedir Kardiyoloji Ne Demek Kardiyoloji Neye Ve Hangi Hastaliklara Bakar Saglik Haberleri

Bas Agrisi Icin Hangi Bolume Gidilir Siddetli Bas Agrisi Icin Hangi Doktordan Randevu Alinmalidir Saglik Haberleri

Kardiyoloji Nedir Hangi Hastaliklara Bakar Saglik Son Dakika Haberler

Hangi Hastaliga Hangi Brans Bakar

Hangi Hastaliga Hangi Doktor Bakar Hangi Bolum Icin Hangi Doktordan Randevu Alinir Fotograf 21

Tansiyona Ne Iyi Gelir Tansiyona Iyi Gelen Gidalar Nelerdir Saglik Haberleri

Hematoloji Nedir Hangi Hastaliklara Bakar Saglik Haberleri

Hangi Hastaliga Hangi Doktor Bakar Hangi Bolum Icin Hangi Doktordan Randevu Alinir Fotograf 21

Yuksek Tansiyon Nasil Tedavi Edilir Kalbinidinlesen

Hangi Hastaliga Hangi Doktor Bakar Hangi Bolum Icin Hangi Doktordan Randevu Alinir Fotograf 21

1 Hamilelikte Tansiyon Hangi Sinirlarda Olmalidir Ne Zaman Tehlikelidir Avrasya Hospital

Hangi Hastaliga Hangi Doktor Bakar Hangi Bolum Icin Hangi Doktordan Randevu Alinir Fotograf 21

Hematoloji Nedir Neye Bakar Hematoloji Bolumu Doktoru Hematolog Hangi Hastaliklara Bakiyor Saglik Haberleri

Hangi Hastaliga Hangi Doktor Bakar Hangi Bolum Icin Hangi Doktordan Randevu Alinir Fotograf 21

Yuksek Tansiyon Icin Hangi Bransa Basvurmaliyim

Akciger Tansiyonunu Diger Hastaliklarla Karistirmayin

Hangi Hastaliga Hangi Doktor Bakar Hangi Bolum Icin Hangi Doktordan Randevu Alinir Fotograf 21

Yuksek Tansiyonun 5 Belirtisi Nedir Canim Doktor Da Youtube

Hangi Hastaliga Hangi Doktor Bakar Hangi Bolum Icin Hangi Doktordan Randevu Alinir Fotograf 21

Hangi Hastaliga Hangi Brans Bakar

Seker Hastaligina Hangi Bolum Bakar Prof Dr Ahmet Ziya Balta

Noroloji Hangi Hastaliklara Bakar Saglik Haberleri